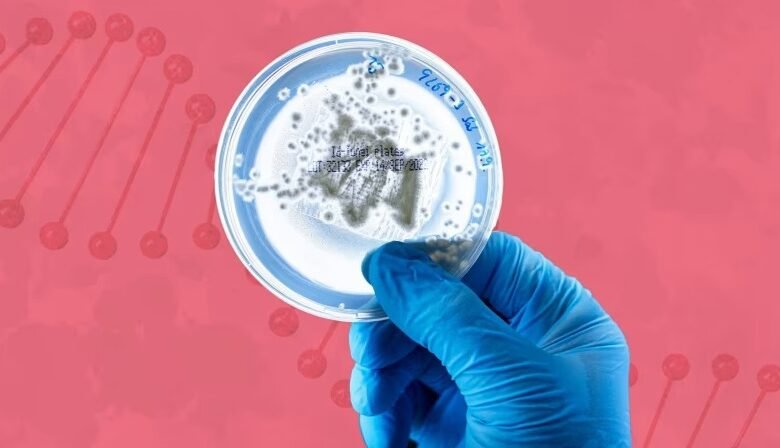

“سباق المليارات لإطالة العمر: من مختبرات كاليفورنيا إلى طموحات المئة عام”
يشهد العالم ثورة علمية واستثمارية غير مسبوقة في مجال أبحاث الشيخوخة. ومع دخول شركات مثل Altos Labs بتمويل ضخم بلغ 3 مليارات دولار، تحوّل حلم العيش حتى عمر 100 وأكثر إلى صناعة ناشئة تجذب كبار المستثمرين والعلماء.
التمويل الضخم وبداية الموجة
إطلاق Altos Labs عام 2022 شكّل لحظة فارقة.
شركات أخرى مثل Retro Biosciences وNewLimit جمعت مئات الملايين لدعم أبحاث إطالة العمر.
النجاحات المبكرة والتحديات القائمة
تجارب ناجحة على الفئران أعادت الأمل في إعادة برمجة الخلايا.
إخفاق شركات مثل Unity Biotechnology يذكّر بأن الطريق ما زال مليئًا بالعقبات.
الدواء بين العلم والاستثمار
يشبّه المحللون الوضع بأدوية السمنة قبل ظهور عقاقير GLP-1 الشهيرة.
علماء يشيرون إلى أن أدوية موجودة بالفعل مثل الميتفورمين وعقاقير السمنة تقلل معدلات الوفاة.
دخول الكبار: شركات الأدوية العالمية
Eli Lilly وNovo Nordisk وصفت أدوية GLP-1 بـ”أدوية طول العمر”.
الأبحاث تكشف عن فوائد تتجاوز إنقاص الوزن لتشمل تحسين أجهزة متعددة بالجسم.
التحدي التنظيمي
لا تعترف الهيئات الصحية بالشيخوخة كمرض، مما يعيق تجارب سريرية مباشرة.
البديل هو استهداف أمراض مرتبطة بالتقدم بالعمر مثل السرطان والزهايمر.
مستقبل المجال: صحة العمر لا طول العمر فقط
التركيز يتحول من مجرد العيش أطول إلى العيش بصحة جيدة أطول فترة ممكنة.
كما قال رئيس Hevolution Foundation: “الناس لا يريدون حياة أطول فقط، بل يريدون حياة أطول وأكثر صحة”.